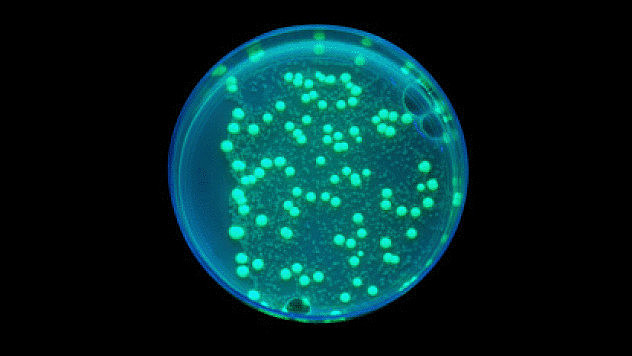
Развитие клеточной теории

-
Первым человеком, который подкрасил образец для исследования под микроскопом, был Ян Сваммердам, голландский натуралист. Сваммердам больше известен за открытие эритроцитов, но он также сделал себе карьеру, разглядывая все под микроскопом. В 1680-е годы он писал о «цветных ликворах» расчлененных червей, которые «позволяют лучше обозначить внутренние части, ведь они одного цвета».
-
В 1740 году знаменитый француз Пьер Луи Моро де Мопертюи предположил, что «слепая судьба» произвела широкий круг индивидуумов, из которых выжили только самые способные. В 1790-х Иммануил Кант отмечал, что это могло бы относиться к изначальному предку жизни. Спустя пять лет Эразм Дарвин написал: «Было бы слишком смелым предположить, что все теплокровные животные произошли от одной живой нити?». Его внук Чарльз решил, что нет никакого «слишком» и предположил.
-
Теория предполагала, что все создания были созданы предварительно — то есть их форма уже была готова до начала их роста.Альтернативой преформизму был эпигенез, идея о том, что жизнь возникает в серии процессов. Первым человеком, который выдвинул эту теорию на фоне любви к преформизму, был Каспар Фридрих Вольф. В 1759 году он написал статью, в которой описал развитие эмбриона от нескольких слоев клеток до человека.
-
Джордж Кювье был первым человеком, который задался таким вопросом. В 1796 году он написал статью о слонах, в которой описал африканские и азиатские разновидности. Также он упомянул о третьем типе слонов, известному науке только по его костям. Кювье отметил ключевые отличия в форме челюсти третьего слона и предположил, что этот вид должен быть совершенно отдельным. Ученый назвал его мастодонтом, но где же тогда живые особи?
-
В 1824 году Анри Дуроче написал о клетке: «Очевидно, что она представляет собой базовую единицу упорядоченного состояния; действительно, все в конечном счете происходит из клетки».Помимо того, что клетка представляет собой основную единицу жизни, клеточная теория также подразумевает, что новые клетки формируются при делении другой клетки на две. Дуроче пропустил эту часть (по его мнению, новые клетки образуются внутри своего родителя).
-
Первым обнаруженным ферментом была амилаза, которую также называют диастазей, и она находится у вас во рту прямо сейчас. Она разбивает крахмал на сахар и была обнаружена французским промышленным химиком Ансельмом Пайеном в 1833 году. Он выделил фермент, но смесь оказалась не очень чистой. Долгое время биологи полагали, что извлечение чистого фермента может быть невозможным.
-
Впервые идею гомеостаза выдвинул Клод Бернар, плодовитый ученый середины 19 века, которому не давала спать слава Луи Пастера (хотя они и были друзьями). Бернар добился серьезных успехов в понимании физиологии, несмотря на то что его любовь к вивисекции уничтожила его первый брак — жена взбунтовалась. Но истинная важность гомеостаза — который он называл milleu interieur — была признана спустя десятилетия после смерти Бернара.
-
Мартинус Бейеринк в 1898 году взял сок из растений табака, больных так называемой мозаичной болезнью. Затем отфильтровал сок через сито настолько мелкое, что оно должно было отфильтровать все бактерии. Когда Бейеринк помазал соком здоровые растения, они все равно заболели. Он повторил эксперимент — и все равно заболели. Бейеринк пришел к выводу, что есть что-то еще, возможно жидкость, что вызывает проблемы. Заразу он назвал vivum fluidum, или растворимыми живыми бактериями.
-
В 1907 кто-то вдруг решил вырастить новые клетки в растворе. Росс Харрисон взял ткани эмбриона лягушки и смог вырастить на их основе новые нервные волокна, которые затем сохранял живыми в течение месяца. Сегодня клеточные образцы можно поддерживать живыми почти бесконечно — ученые до сих пор экспериментируют с клеточными тканями женщины, которая умерла 50 лет назад.
-
До недавней кончины, британский ученый Фредерик Сэнгер был единственным живым человеком, который получил две Нобелевских премии. Именно работа на вторую премию привела к тому, что он попал наш в список. В 1980 он получил главный научный приз вместе с Уолтером Гилбертом, американским биохимиком. В 1977 году они опубликовали метод, который позволяет выяснить последовательность строительных блоков в цепи ДНК.
Want to make a timeline like this?
Use Timetoast to turn dates, events, milestones, and phases into a clear visual timeline you can build and share. Timetoast is a timeline maker for work, school, research, and stories.